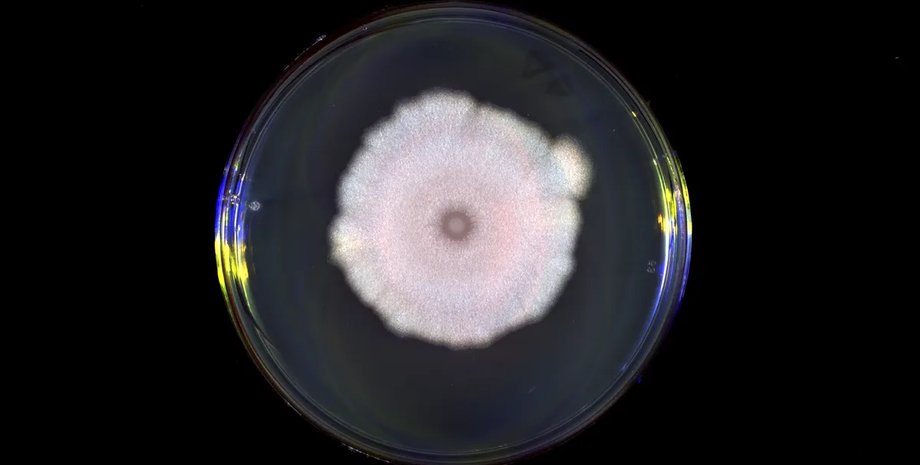
еволюція вірусів

Не варто вірити усьому, що говорять: дезінформацію вперше використовували зовсім не люди (відео)
Дослідники щойно виявили, що віруси насправді підслуховують розмови один одного, але часом вони також отримують неправдиву інформацію.
Земля є домівкою для неймовірної кількості видів. Усі живі істоти на планеті покладаються на інформацію з довкілля під час ухвалення рішень, і тепер учені з'ясували, що навіть віруси можуть навчатися в інших вірусів. Дослідження також показали, що поради від іншого виду часом можуть збити їх зі шляху, пише Фокус.
У Фокус. Технології з'явився свій Telegram-канал. Підписуйтесь, щоб не пропускати найсвіжіші та найзахопливіші новини зі світу науки!
Коли вірус проникає в клітину, він не завжди одразу перетворює її на фабрику з виробництва вірусів, вбиваючи її в процесі — натомість це загарбник перебуває в сплячому стані. Розуміння того, коли і чому віруси приймають це рішення все ще залишається загадкою, але може розповісти вченим дещо про еволюцію, а також може допомогти нам боротися з ними або використовувати їхню силу в міру необхідності.
Фаги — віруси, які заражають бактерії, а не тварин або рослини. Дослідники також запропонували їх як рішення проблеми стійкості до антибіотиків, оскільки, хоча бактерії можуть еволюціонувати, щоб боротися з ними. Ба більше, дослідження показали, що фаги також можуть адаптуватися у відповідь і підтримувати свою ефективність. І все ж, за словами аспірантки Ребекки Вудхемс з Ексетерського університету у Великій Британії, використання фагів у медичних цілях перебуває на початковій стадії. Тепер вчені прагнуть їх зрозуміти.
У своєму дослідженні вчені виявили, що рішення про знищення або перехід у сплячий стан залежить від конкретної ситуації. Наприклад, коли доступно багато бактерій, факг має обрати лізис і прагнути заразити потенційних господарів. Коли багато з них уже знищено, і залишилося мало, безпечніше залишатися в тіні й чекати кращих часів. За словами вчених, це щось на зразок сплячки, коли їжі мало, але без сигналів про наближення зими.
Ще 10 років тому вчені виявили, що частинки фагів посилають хімічні сигнали у вигляді пептидів, які дають іншим частинкам інформацію про стан запасів їжі. Коли концентрація пептидів низька, знищується менше бактерій, тож, імовірно, безпечно харчуватися тією, до якої потрапив вірус. Високі концентрації пептидів сигналізують про масове винищення господаря, вказуючи на те, що, можливо, краще зачекати, поки популяція відновиться. Коли бактерії роблять щось подібне, це називається кворумним зондуванням.
За словами Вудхем, такий підхід безсумнівно має переваги для будь-якого виду фагів, який його використовує. Учені також виявили, що фаги можуть звертати увагу на пептиди, які продукують інші види фагів. Однак тут усе стає трохи складнішим.
За словами Робін Менлі з Ексетера, коли фаг виявляє сигнали від іншого виду, він, найімовірніше, залишиться в сплячому стані, замість того щоб вбивати клітину і вивільняти більше вірусів. Цікаво, що це відбувається, навіть якщо повідомлення не призначалося для нього і не відображає його власну ситуацію.
Не менш цікавим виявилося й те, що хоча деякі види фагів можуть виявляти пептиди один одного, для інших комунікація є односпрямованою. Наприклад, вірус А може розуміти вірус В, але вірус В не вловлює сигнал А. За словами дослідників, це може бути корисним для вірусу, який відправив сигнал, запобігаючи загибелі клітин від іншого вірусу, але також може мати свою ціну для вірусу, який реагує. Іншими словами, вірусна комунікація — це не просто співпраця, а часом чистої води маніпуляція.
Простими словами, дезінформаційні кампанії насправді були придумані зовсім не людьми — насправді це еволюційний винахід. Однак учені передрікають, що якщо дезінформація занадто ефективна, вона сприятиме появі мутантного штаму фага, який не може вловлювати сигнали інших.
Нагадаємо, раніше ми писали про те, що у Світовому океані виявлено сотні гігантських вірусів: учені не знали про їхнє існування раніше.
Раніше Фокус писав про те, що вчені виявили гігантський вірус із найдовшим хвостом: ховається в Тихому океані.
Під час написання використовували матеріали Cell, IFLScience.